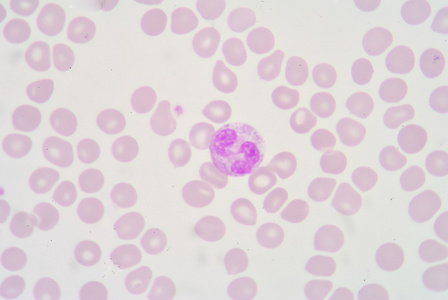
中性粒细胞照片

嗜中性粒细胞图片
嗜中性粒细胞,细胞,显微镜,水平画幅,无人
图片尺寸1200x900hypersegmented嗜中性粒细胞
图片尺寸1200x1022嗜中性粒细胞
图片尺寸1100x1116嗜中性粒细胞,细胞,显微镜,水平画幅,无人
图片尺寸1200x900嗜中性粒细胞
图片尺寸1100x1100嗜中性粒细胞,细胞,显微镜,水平画幅,无人
图片尺寸1200x900嗜中性粒细胞,细胞,显微镜,水平画幅,无人
图片尺寸1200x800嗜中性粒细胞,细胞,显微镜,水平画幅,无人
图片尺寸1200x900嗜中性粒细胞
图片尺寸1200x803hypersegmented嗜中性粒细胞
图片尺寸1200x1022嗜中性粒细胞
图片尺寸1108x1100
嗜中性粒细胞
图片尺寸193x249嗜中性粒细胞,细胞,血小板,白细胞,红细胞
图片尺寸1200x900嗜中性粒细胞
图片尺寸1200x800
中性粒细胞照片
图片尺寸448x300
微核(micronucleus, 简称mcn),也叫卫星核,是真核类生物细胞中的一种
图片尺寸891x900
中性粒细胞 5.淋巴细胞 6.单核细胞 7.血小板
图片尺寸1080x810
hypersegmented 中性粒细胞.
图片尺寸352x300兔嗜中性粒细胞
图片尺寸640x473
中性粒细胞
图片尺寸685x1023
猜你喜欢:小红细胞图片血涂片细胞形态图片嗜酸性粒细胞图片单核细胞图片中性粒细胞镜下图片嗜碱性粒细胞图片淋巴细胞图片巨噬细胞图片嗜中性粒细胞浆细胞图片中性粒细胞图片中性粒细胞淋巴细胞中性粒细胞工作细胞中性粒细胞结构图中性粒细胞图片手绘中性粒细胞吞噬细菌中性粒细胞绘图中性粒细胞手绘图中性粒细胞中性粒细胞高中性粒细胞特点中性粒细胞偏低中性粒细胞吞噬中性粒细胞形态中性粒细胞手绘嗜碱性粒细胞中性粒细胞绘图红蓝中性粒细胞吞噬手绘图中性粒细胞红蓝铅笔图中性粒细胞百分比偏低甜甜的女生网名回家过年 简笔画皇后 卡通猫咪体内绦虫女的飞机场图片大全QQ图标2021花苗头像正义的伙伴fate赛博朋克酒保行动辱华情满四合院尤凤霞电子学生卡刘星情侣头像